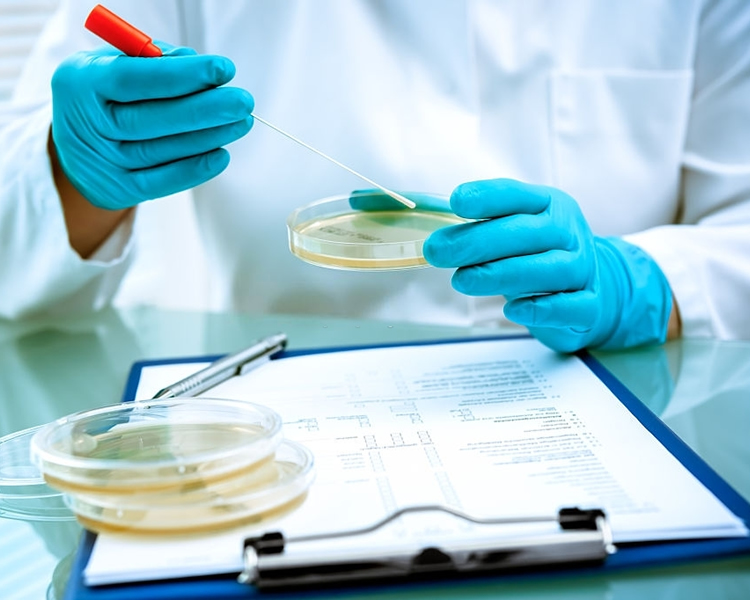

Ensuring the Highest Standards in Food Safety & Quality.
We have our own in-house microbiology laboratory and nutrient laboratory to ensure that our quality and food safety standards are maintained at the highest possible levels.
-
Food Safety Management System
As a global producer of fruits and food products, it is our commitment to manage the safety of our products for the well-being of our consumers. As such, all our processes abide by the stringent requirement of the ISO 22000 Food Safety Management System so that our consumers can enjoy our products with peace of mind.
-
Stringent Quality Control
At ROMPINE, we have put in place stringent QA procedures to ensure the safety of our products so that consumers can enjoy the best possible quality that ROMPINE can offer.